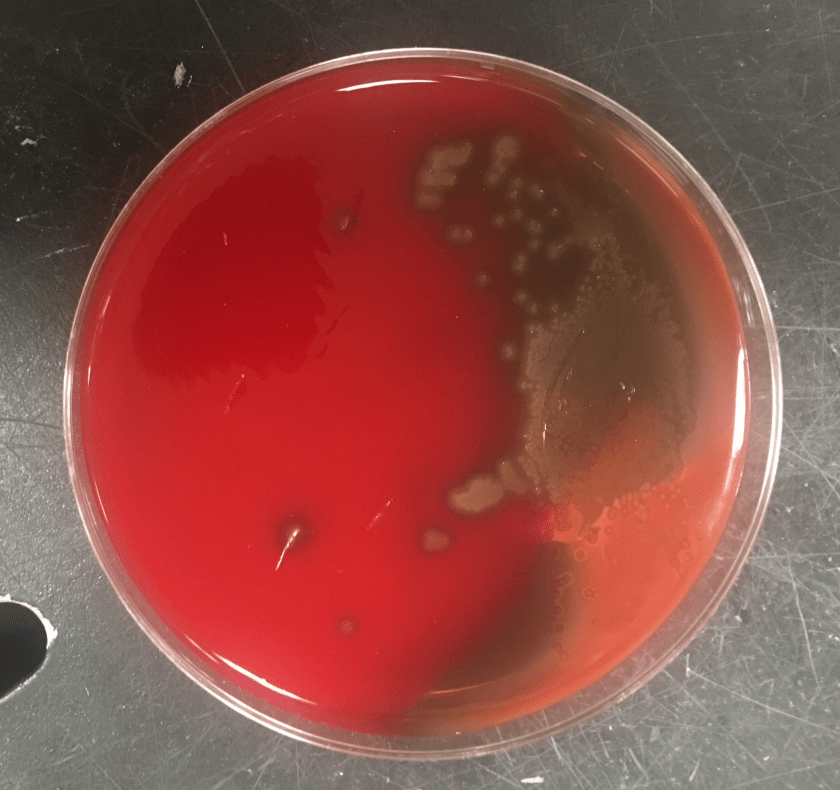
streppseudo3.png

A 68-year-old gentleman with a 50 pack year smoking history, COPD, and poorly differentiated lung cancer diagnosed after asymptomatic lung cancer screening, and status-post lobectomy presented to the pulmonology clinic for a one year follow-up. At this visit, the patient endorsed ongoing mild shortness of breath when climbing stairs and non-productive cough, but no fevers or chills. He underwent chest CT, which was notable for an enlarging right paratracheal LN as compared to a CT from six months prior, and RML collapse thought secondary to either mucous plugging versus tumor involvement of the bronchus. After a discussion with his physician, the patient agreed to undergo a flexible bronchoscopy with bronchoalveolar lavage (BAL) and lymph node biopsy instead of waiting six months for a repeat CT.

Lab Identification
Gram smear of BAL fluid revealed moderate polys, few squamous epithelial cells, and moderate gram positive cocci. Colony morphology was notable for small, smooth-edged colonies displaying alpha hemolysis, that were bile insoluble. The organism was determined to be Streptococcus pseudopneumoniae by MALDI-TOF.
Discussion
Streptococcus pseudopneumoniae is a novel species of Streptococcus that belongs to the mitis group first described in 2004 by Arbique in an analysis of lower respiratory tract samples. Gram smear reveals GPCs without a capsule, and culture shows tiny, pinpoint, smooth-edged colonies with alpha-hemolysis. It may also resemble a smaller version of typical pneumococcal “checkers,” with raised edges and a depressed center. Species identification has been challenging given the greater than 99% homology of the 16S rRNA gene among S. mitis, S. oralis, S. pneumoniae, and S. pseudopneumoniae (however DNA-DNA similarity of the entire genome is < 60%). It was initially characterized phenotypically, based on its bile insolubility and variable optochin susceptibility (resistance to optochin in the presence of 5% CO2, and susceptibility at ambient atmosphere). The latter is thought to be due to a novel mutation in the F0F1 ATP Synthase subunit c.
The incidence of S. pseudopneumoniae is believed to be low, but it may be underreported due to labs identifying it as an atypical pneumococci. Furthermore, the pathologic significance is poorly understood. Jensen et al. performed molecular mapping of tonsillar crypt microbiota in healthy subjects and patients with recurrent tonsillitis, and found that S. pseudopneumoniae was present in all samples. Multiple retrospective studies looking at patients with S. pseudopneumoniae in their sputum compared to matched controls found that it was more likely to be present in patients with COPD (Keith et al.) and pneumonia (Laurens et al.). It has also been isolated from blood, ascitic fluid, and conjunctival samples. One case report from 2014 described a case of bleb-related endophthalmitis in a 63 year old man who had undergone glaucoma surgery 46 years prior.
A real-time PCR assay specific for S. pseudopneumoniae has been developed by Sistek et al. based on a mutation in the recA gene; however, it has yet to be validated.
As S. pseudopneumoniae belongs to the viridans group, susceptibility breakpoints for determining MIC are based on this group rather than S. pneumoniae. It is generally susceptible to vancomycin, carbapenems, and quinolones, and resistant to macrolides and tetracycline.
References
Janda et al. “The Genus Streptococcus Part II: New Species and Pathogens in the “Miscellaneous” Streptococci and “Viridans” Streptococci Groups.” Clinical Microbiology Newsletter Vol. 36, No. 21 November 1, 2014
Kawakami et al. “Late-onset bleb-related endophthalmitis caused by Streptococcus pseudopneumoniae.” International Ophthalmology (2014) 34:643–646 DOI 10.1007/s10792-013-9835-2
-Sean Bullis is a 4th year medical student at the University of Vermont College of Medicine.

-Christi Wojewoda, MD, is the Director of Clinical Microbiology at the University of Vermont Medical Center and an Assistant Professor at the University of Vermont.